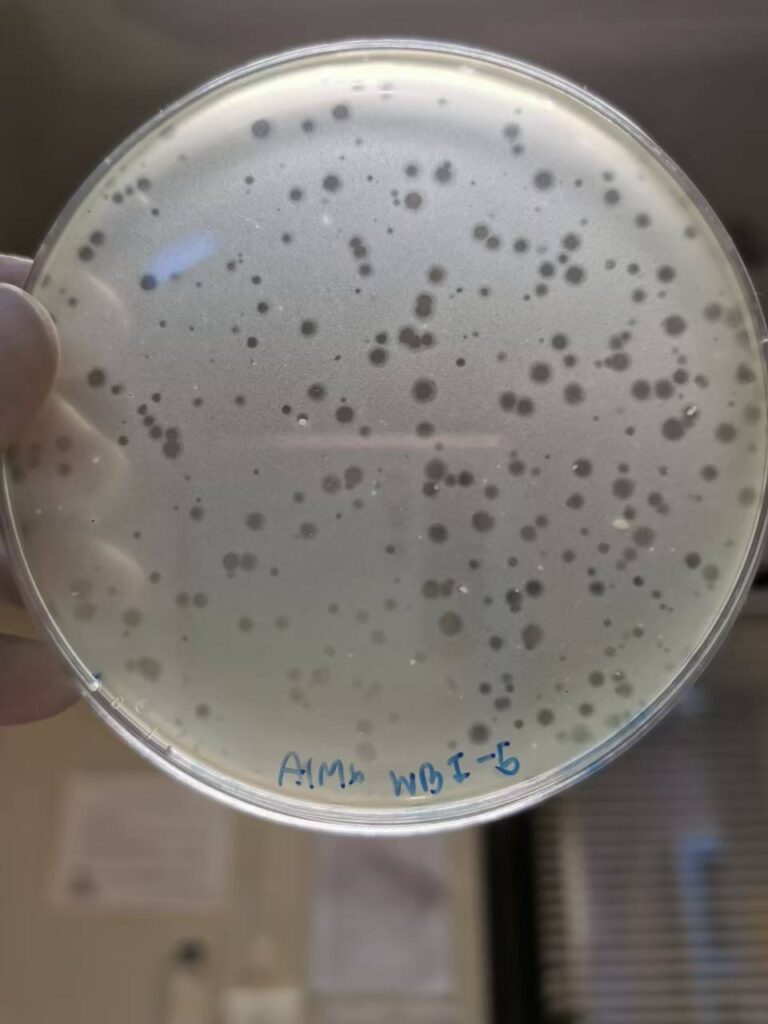

นักวิจัย สถาบันวิจัยจุฬาภรณ์ พัฒนาเทคโนโลยีกลุ่มจุลินทรีย์ ระบุแหล่งกำเนิดน้ำเสียในประเทศไทย (Microbial Source Tracking) แก้ปัญหามลพิษและโรคทางน้ำ ฟื้นฟูและจัดการคุณภาพแหล่งน้ำธรรมชาติ เป็นที่ยอมรับระดับนานาชาติ ร่วมมือกับการประปาฯ กรมปศุสัตว์ กรมควบคุมมลพิษ ใช้ประโยชน์งานวิจัย สอดรับยุทธศาสตร์ชาติ 20 ปี เร็วนี้ ๆ เตรียมรับรางวัลผลงานวิจัยดีเด่นแห่งชาติ ปี 2565 ในงานวันนักประดิษฐ์แห่งชาติ ประจำปี 2564 – 2565 ที่ศูนย์นิทรรศการและการประชุมไบเทค บางนา
ปัจจุบัน แหล่งน้ำธรรมชาติ ได้แก่ น้ำฝน น้ำแม่น้ำ ลำคลอง น้ำใต้ดินและน้ำทะเล เกิดความเสื่อมโทรมเป็นอย่างมาก ผลมาจากการปล่อยมลพิษจากแหล่งกำเนิดต่างๆ ทั้งแบบที่ทราบจุดแน่นอน และแบบไม่ทราบจุดแน่นอน เช่น การรั่วไหลของท่อรวบรวมน้ำเสียใต้ดิน น้ำฝนที่ชะพาสิ่งสกปรกลงสู่ดินและแหล่งน้ำ ตลอดจนสิ่งปฏิกูลจากสัตว์ป่าและนกน้ำ เป็นต้น อย่างไรก็ตาม มลพิษทางน้ำแบบไม่ทราบแหล่งกำเนิดแน่ชัด กลับมีปริมาณที่หลากหลายและส่งผลกระทบต่อภาวะมลพิษที่ลงสู่แหล่งน้ำธรรมชาติได้มากกว่า ซึ่งยังคงไม่มีระบบบริหารจัดการ หรือระบบติดตาม ตรวจสอบ ที่เป็นรูปธรรม ทำให้ประเทศไทยสูญเสียงบประมาณในการจัดการคุณภาพน้ำและน้ำเสียในปี พ.ศ.2562 สูงถึง 2,154 ล้านบาท คิดเป็นร้อยละ 50 ของงบประมาณทั้งหมดที่ใช้ในการบริหารจัดการมลพิษและสิ่งแวดล้อม
ดร.ขวัญรวี สิริกาญจน นักวิจัยเชี่ยวชาญ จากสถาบันวิจัยจุฬาภรณ์ ในฐานะหัวหน้าโครงการ กล่าวว่า จากผลของโครงการวิจัย โดยได้รับการสนับสนุนทุนวิจัยจาก สถาบันวิจัยจุฬาภรณ์ และ สำนักงานกองทุนสนับสนุนการวิจัย (สกว.) ทำให้ได้ข้อมูลเชิงลึกที่มีผลกระทบสูงต่อประเทศ ช่วยสนับสนุนการแก้ปัญหามลพิษทางน้ำ คุณภาพน้ำเสื่อมโทรม และลดปัญหาข้อขัดแย้งจากการลักลอบปล่อยน้ำเสียลงสู่แหล่งน้ำธรรมชาติ ซึ่งประเทศไทยได้ประสบปัญหานี้มาอย่างต่อเนื่องและยาวนาน ผลการวิจัยได้รับการต่อยอดร่วมกับหน่วยงานต่างๆ ได้แก่ กรมควบคุมมลพิษ กระทรวงทรัพยากรธรรมชาติและสิ่งแวดล้อม การประปานครหลวง และกรมปศุสัตว์ กระทรวงเกษตรและสหกรณ์ เพื่อใช้ประโยชน์งานวิจัยในการระบุแหล่งปนเปื้อนมลพิษ พร้อมกำหนดแผนจัดการฟื้นฟูคุณภาพน้ำให้สอดคล้องกับยุทธศาสตร์ชาติ 20 ปี ด้านการเติบโตที่เป็นมิตรกับสิ่งแวดล้อมเพื่อการพัฒนาอย่างยั่งยืน แผนแม่บทบริหารจัดการทรัพยากรน้ำ 20 ปี ได้อย่างเมาะสมกับงบประมาณและความรุนแรงของปัญหาในพื้นที่ต่างๆ
“โดยเฉพาะการส่งเสริมแนวคิดใหม่ ในการขับเคลื่อนเศรษฐกิจด้วยทรัพยากรธรรมชาติทางทะเลและชายฝั่ง หรือ Blue Economy ให้เกิดการกระตุ้นการท่องเที่ยวทางน้ำ และเพื่อเตรียมพร้อมให้ไทยเป็นผู้นำด้านการจัดการสิ่งแวดล้อมที่ดีที่สุดในอาเซียน อันเป็นการยกระดับคุณภาพชีวิตความเป็นอยู่ โดยเฉพาะด้านสุขภาพของประชาชนชาวไทย โดยลดการพึ่งพาเทคโนโลยีและผู้เชี่ยวชาญจากต่างประเทศ ผลสำเร็จของโครงการเป็นที่ยอมรับในระดับสากล โดยได้เผยแพร่ในวารสารวิชาการระดับนานาชาติ กว่า 13 ผลงาน อ้างอิงผลกระทบเชิงวิชาการในระดับนานาชาติ 95 ครั้ง และคว้ารางวัลผลงานวิจัยระดับนานาชาติ จำนวน 6 รางวัล รวมทั้ง เป็นผลงานเดียวที่ได้รับรางวัลผลงานวิจัยดีเด่นแห่งชาติ ประจำปี 2565 จากสำนักงานการวิจัยแห่งชาติ (วช.) กระทรวงการอุดมศึกษาวิทยาศาสตร์ วิจัยและนวัตกรรม (อว.) พร้อมจัดแสดงผลงานในงานวันนักประดิษฐ์ ประจำปี 2565 ที่ศูนย์นิทรรศการและการประชุมไบเทค บางนา กรุงเทพฯ นับว่าเป็นการสร้างความเข้มแข็งให้แก่ฐานทรัพยากรวิจัย และการแข่งขันเชิงวิชาการของประเทศ” ดร.ขวัญรวีฯ กล่าวเสริม
สำหรับการใช้เทคโนโลยีกลุ่มจุลินทรีย์ในการตรวจระบุแหล่งกำเนิดน้ำเสียในประเทศไทย (Microbial Source Tracking ; MST) มีกรอบการทำงานครอบคลุมตั้งแต่ การพัฒนาวิธีการตรวจวัดจุลินทรีย์ในระบบทางเดินอาหารที่จำเพาะกับมนุษย์และสัตว์แต่ละชนิด โดยอาศัยการตรวจวัดเชื้อไวรัสที่จำเพาะกับแบคทีเรีย หรือเรียกว่า แบคเทอริโอเฟจ และการตรวจทางอณูชีวโมเลกุลของสารพันธุกรรมด้วยวิธีพีซีอาร์ และพีซีอาร์เชิงปริมาณ การศึกษาลักษณะเฉพาะต่างๆ เช่น ความคงทนในสิ่งแวดล้อม ปัจจัยที่มีผลต่อประสิทธิภาพการวิเคราะห์ จนได้เป็นเทคโนโลยีการตรวจแหล่งปนเปื้อนในห้องปฏิบัติการที่มีความพร้อม ทดสอบวิธีที่พัฒนาใหม่ในพื้นที่จริงของประเทศ พัฒนาเทคนิคตัวอย่าง ประเมินความเสี่ยงด้านสุขภาพของผู้สัมผัสน้ำปนเปื้อน และต่อยอดองค์ความรู้พัฒนาเครื่องมือแบพกพาสำหรับตรวจวัดจุลินทรีย์เพื่อระบุการปนเปื้อนในภาคสนาม การพัฒนาโครงสร้างพื้นฐานด้านห้องปฏิบัติการวิจัยขั้นสูง ที่สามารถรองรับการแก้ไขปัญหาในโจทย์ใหม่ที่มีความท้าทายสูง เช่น การเฝ้าระวังเชื้อก่อโรคอุบัติใหม่โควิด-19 ในน้ำเสีย ทำให้ไทยสามารถตอบสนองปัญหาได้อย่างรวดเร็ว และเท่าทันต่อสถานการณ์
สุรเชษฐ ศิลานนท์ รายงาน